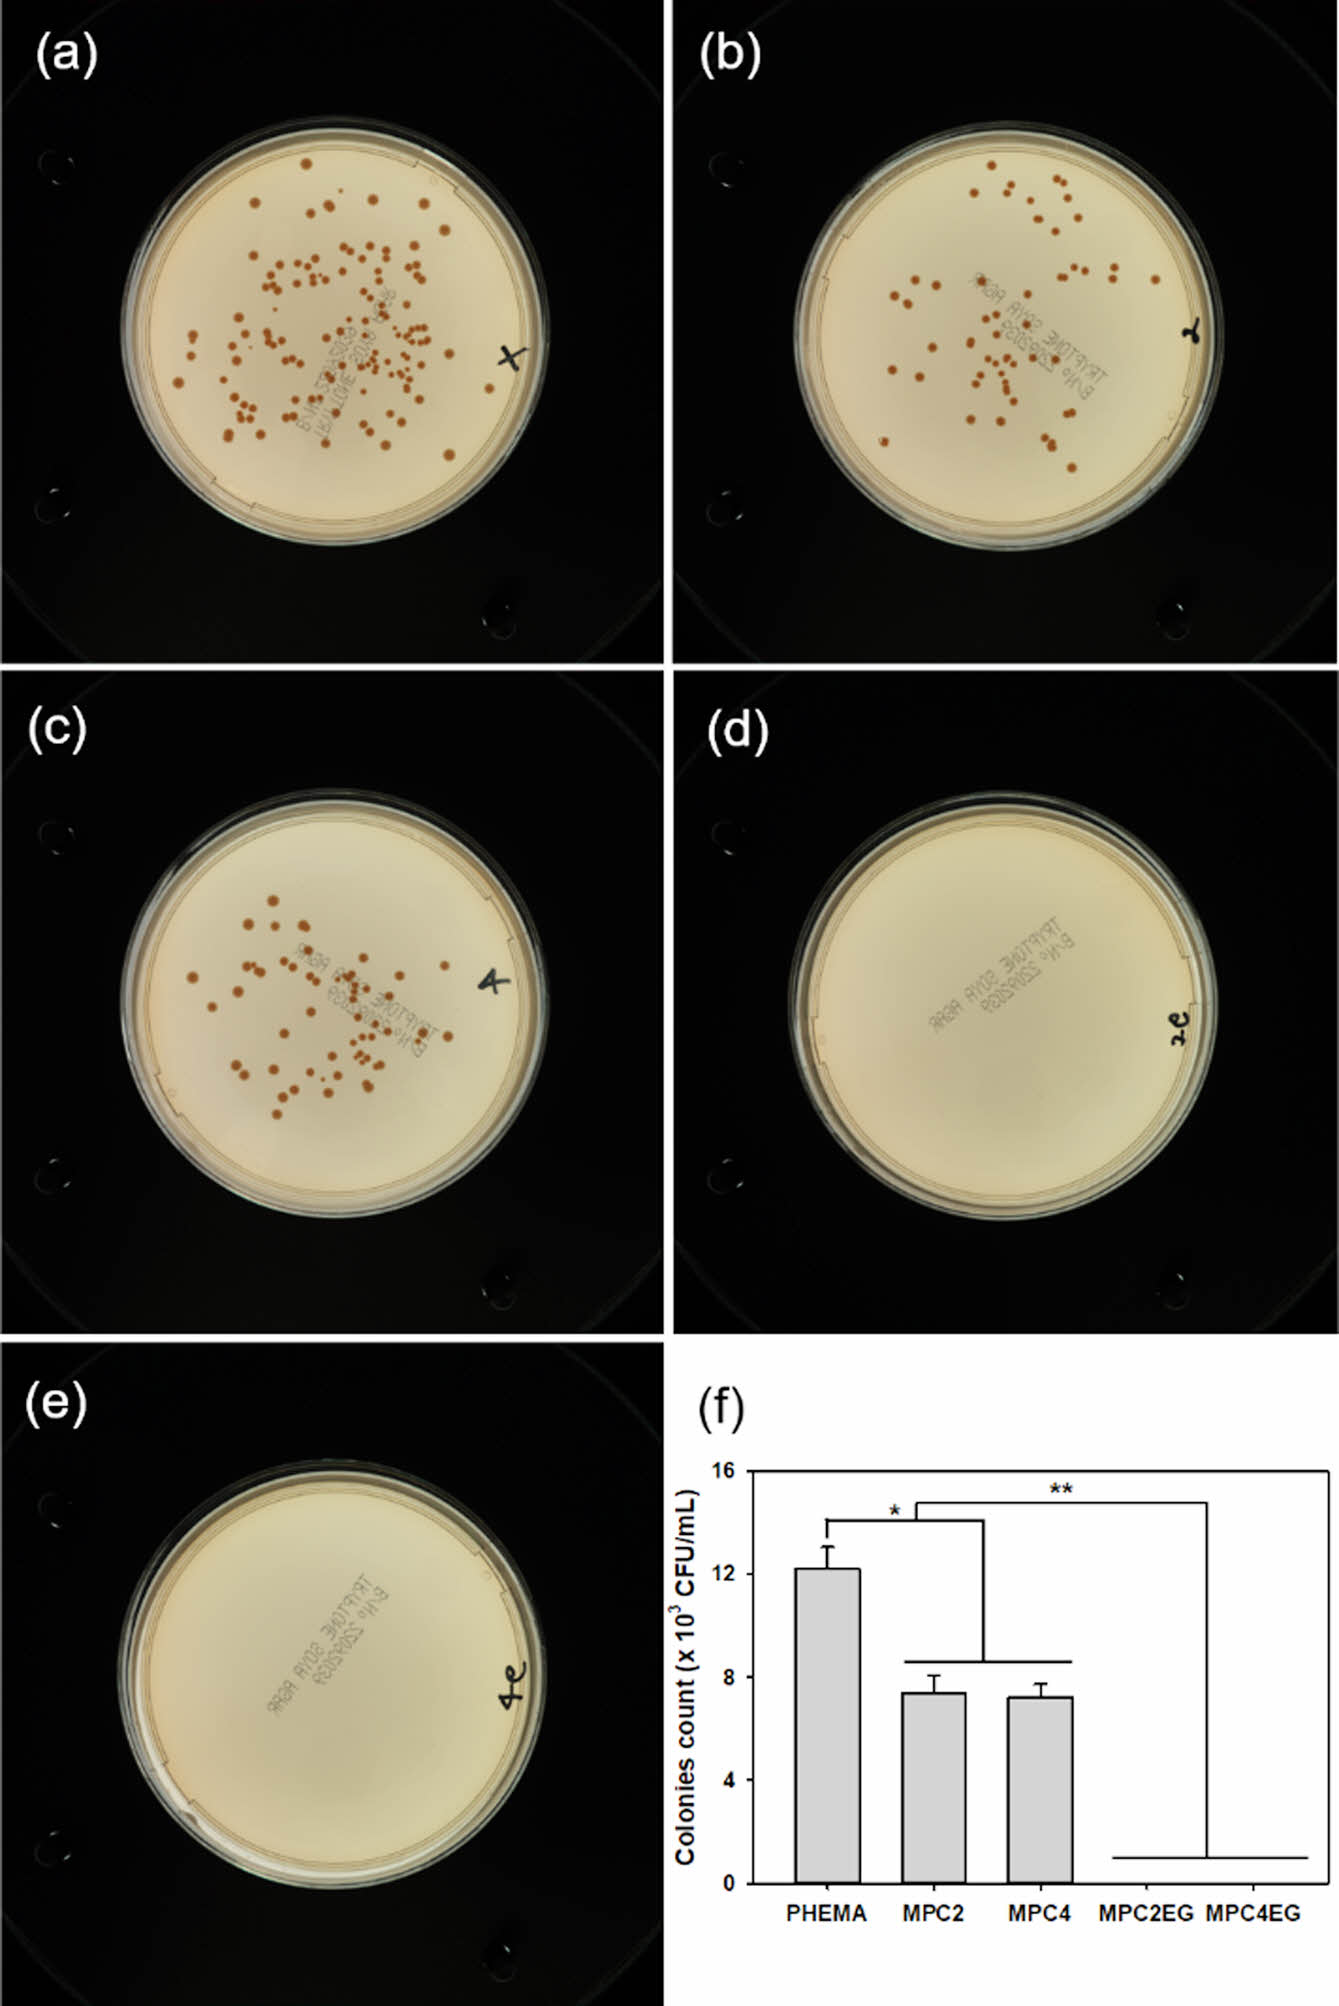

- Antioxidant and Antifouling Activities of Acrylic Hydrogel Contact Lenses Coated with Phosphorylcholine Polymer and Natural Polyphenol
Seo Hyun Kim, Seong Dae Jeong*, Hyun Mee Lee**, Ki Hong Kim**, Yoon Soo Han, and Young-Jin Kim†

Department of Advanced Materials and Chemical Engineering, Daegu Catholic University, Gyeongsan 38430, Korea
*Department of Biomedical Engineering, Daegu Catholic University, Gyeongsan 38430, Korea
**Department of Optometry and Vision Science, Daegu Catholic University, Gyeongsan 38430, Korea
- 포스포릴콜린 고분자와 천연 폴리페놀이 코팅된 아크릴 하이드로젤콘택트렌즈의 항산화성과 단백질 흡착 억제능
대구가톨릭대학교 신소재화학공학과, *대구가톨릭대학교 의공학과, **대구가톨릭대학교 안경광학과
Reproduction, stored in a retrieval system, or transmitted in any form of any part of this publication is permitted only by written permission from the Polymer Society of Korea.
The functional acryl hydrogel contact lenses have attracted great attention because of their superior antioxidant and antifouling activities, resulting that they can be worn for a long time. In this study, acryl hydrogel contact lenses coated with phosphorylcholine polymer and EGCG, such as MPC2EG and MPC4EG, were prepared to improve antioxidant and antifouling activities. The resulting contact lenses exhibited higher optical transparency, oxygen permeability, and blue light blocking ability compared with PHEMA lens. In addition, they exhibited highly enhanced radical scavenging activity and antifouling activity. They removed most of DPPH and ABTS radical, and the suppressed the adhesion of albumin, lysozyme, and γ-globulins on the surfaces of contact lenses. In particular, they displayed superior antimicrobial activities against Staphylococcus aureus and E. Coli.
항산화성과 단백질 흡착 억제능이 극대화된 기능성 아크릴 하이드로젤 콘택트렌즈는 부작용 없이 장시간 착용이 가능하기 때문에 최근 많은 관심을 받고 있다. 본 연구에서는 포스포릴콜린 고분자와 천연 폴리페놀인 에피갈로카테킨 갈레이트(EGCG)로 렌즈 표면을 코팅함에 의해서 항산화성과 단백질 흡착 억제능이 극대화된 아크릴 하이드로젤 콘택트렌즈인 MPC2EG 및 MPC4EG를 제조하였다. 제조된 콘택트렌즈는 높은 광학 투명도를 보였으며, 코팅 처리하지 않은 PHEMA 렌즈 대비 높은 산소투과율과 청색광 차단율을 보였다. 또한 여러 종류의 라디칼에 대해서 매우 뛰어난 라디칼 제거능을 보였고, 다양한 단백질에 대해서는 우수한 단백질 흡착 억제능을 보였다. 특히 감염성 안질환 원인균인 포도상구균과 대표적인 그램 음성균인 대장균에 대해서 매우 우수한 항균성을 보였다.
Acryl hydrogel contact lenses coated with phosphorylcholine polymer and epigallocatechin gallate, such as MPC2EG and MPC4EG, were prepared to improve antioxidant and antifouling activities. The resulting contact lenses exhibited higher optical transparency, oxygen permeability, and blue light blocking ability compared with PHEMA lens. In addition, they exhibited highly enhanced radical scavenging activity, antifouling activity, and antimicrobial activity.

Keywords: acryl hydrogel contact lens, antioxidant activity, antifouling activity, phosphorylcholine polymer, natural polyphenol.
이 결과물은 2022년도 대구가톨릭대학교 학술연구비 지원에 의한 것임.
저자들은 이해상충이 없음을 선언합니다.
하이드록시에틸 메타크릴레이트(2-hydroxyethyl methacrylate, HEMA)를 주성분으로 사용하여 다양한 단량체와의 조합으로 중합된 소프트 하이드로젤 콘택트렌즈는 우수한 함수율, 기계적 물성 및 생체적합성으로 인해서 시력교정 및 미용을 목적으로 사용이 증가하고 있는 추세이다.1-3 또한 최근에는 단백질 흡착 억제, 약물전달, 생체 신호 감지 등의 다양한 기능성이 부여된 하이드로젤 콘택트렌즈가 개발되고 있다.4-7
건강에 대한 관심의 증가는 야외 활동에 대한 선호도를 증가시키고 이로 인해서 사람들이 고에너지 자외선에 노출되는 시간이 늘어나고 있다. 그 결과 안구 내에서 활성산소(reactive oxygen species, ROS)의 생성을 증가시켜 수정체 상피세포의 사멸을 유도하고 녹내장과 백내장 등과 같은 각종 안질환을 유발시키시는 것으로 보고되고 있다.8-10 또한 최근 태블릿 피시(tablet personal computer)나 스마트폰과 같은 개인용 휴대 전자기기의 장시간 사용에 의해 안구 내 활성산소의 발생이 과도하게 증가하여 안질환을 유발하는 문제점이 빠른 속도로 증가하고 있다.2,8 이는 전자기기의 디스플레이에 사용된 발광 다이오드(light emitting diode, LED)에서 많이 방출되는 380-480 nm의 청색광에 기인하며, 망막 앞쪽에서 상이 형성되는 색수차를 유발한다.11,12 특히 청색광에 장시간 노출되면 활성산소가 비이상적으로 발생하여 망막세포를 손상시키고 또한 염증반응을 유발하는 문제점이 발생한다.
망막에는 가시광선을 인식하기 위해 빛을 받아들이는 광수용세포가 존재하기 때문에 빛을 받아들이기에 최적화되어 있지만 이로 인해서 빛에 의한 독성도 나타난다. 그 중에서도 가시광선의 청색광에 장시간 노출되면 망막이 광화학손상을 입게 된다.11 이러한 문제를 해결하기 위해서 안구와 접촉이 없는 안경렌즈에는 염료를 착색제로 사용하여 청색광을 차단하지만 안구와 직접적으로 접촉하는 콘택트렌즈의 경우 인체에 무해한 방법으로 청색광을 차단하는 방법이 아직 개발되지 못하고 있다.
콘택트렌즈는 안구에 직접 접촉하므로 착용 시간이 증가할수록 눈물에 포함되어 있는 단백질이나 지질 등이 렌즈 표면에 흡착되기 쉽고, 그 중에서도 소프트 콘택트렌즈의 경우 흡착된 단백질을 제거하기에도 어려움이 있다.13,14 결국 콘택트렌즈에 흡착된 단백질은 충혈, 이물감 등과 같은 착용감 저하와 시력저하를 유발할 뿐만 아니라 거대유두 결막염이나 표층점막 각막염 등과 같은 합병증을 유발하기도 한다. 또한 이들 흡착된 단백질은 콘택트렌즈의 산소투과도를 감소시켜 각막 표피에 미생물 감염증을 유발시키는 포도상구균이나 녹농균 등의 부착을 촉진시킨다는 문제점도 있다.13 특히 콘택트렌즈의 보관 용기, 세척액 및 보관액의 오염에 따른 세균의 증식도 콘택트렌즈의 사용을 제한할 수 있다. 따라서 장시간의 콘택트렌즈 착용이 안구에 직접적인 문제점을 유발하지 않기 위해서는 렌즈가 항산화성, 청색광 차단능 및 단백질 흡착 억제능을 모두 가지고 있어야 한다.
에피갈로카테킨 갈레이트(epigallocatechin gallate, EGCG)는 녹차의 주요 활성 성분이며 식물세포의 생성 및 활성화를 촉진하는 식물성 폴리페놀에 포함된다.7,15,16 EGCG는 항산화성, 항균성 및 항염증성 등과 같은 다양한 약리적 기능을 가지는 것으로 알려져 있고, 심혈관 질환의 예방에서 우수한 효과가 있는 것으로 보고되고 있다. 특히 고농도로 사용되어도 인체에 독성을 거의 보이지 않는 장점을 가지고 있다.17 메타크릴로일옥시에틸 포스포릴콜린(2-methacryloyoxyethyl phosphorylcholine, MPC)을 함유하는 고분자는 세포막의 인지질 유사체로서 인공재료와 생체시스템 사이에 우수한 계면을 제공해 주는 물질이다.14,18,19 이들 고분자에 존재하는 MPC는 쯔비터이온(zwitterion) 특성을 가지고 있기 때문에 MPC 단위체가 물분자에 의해 쉽게 수화된다. 이러한 표면특성으로 인해서 포스포릴콜린 고분자는 단백질 흡착이나 세포 점착을 억제시키는 기능이 있다.
따라서 본 연구에서는 항산화성이 우수한 것으로 알려진 천연 폴리페놀인 EGCG를 렌즈의 표면에 도입하여 소프트 콘택트렌즈의 단점인 ROS의 생성을 억제시킬 뿐만 아니라 항균성도 부여하고자 하였다. 또한 콘택트렌즈 표면에 단백질 흡착을 억제시키기 위해서 포스포릴콜린 고분자도 아크릴 하이드로젤 콘택트렌즈 표면에 코팅하였다. 제조된 콘택트렌즈의 표면 형태 및 특성 변화에 대해서 조사하였고, 또한 도입된 EGCG 및 포스포릴콜린 고분자가 항산화성, 항균성, 단백질 흡착 및 청색광 투과율에 미치는 영향을 평가하였다.
시약 및 재료. HEMA, methacrylic acid(MMAc), N-vinyl pyrrolidone(NVP), dimethylacrylamide(DMA), triethylene glycol dimethacrylate(TEGDMA), MPC, N,N'-methylenebisacrylamide, 히아루론산(hyaluronic acid sodium salt), 알부민(bovine serum albumin), 리소자임(lysozyme), 글로불린(γ-globulins from bovine blood), EGCG, fluorescamine, 2,2-diphenyl-1-picrylhydrazyl (DPPH), 2,2'-azino-bis(3-ethylbenzothiazoline-6-sulphonic acid)(ABTS), 2,2'-azobisisobutyronitrile(AIBN), potassium persulfate와 dimethyl sulfoxide(DMSO)는 Sigma-Aldrich Co. (USA) 제품을 구입하여 사용하였다. Dulbecco’s phosphate buffered saline(DPBS, pH 7.4)은 Gibco BRL(USA)에서 구입하였다. 그 외의 사용된 시약과 용매는 일반 회사에서 구입하였으며, 추가적인 정제과정 없이 사용하였다.
아크릴 콘택트렌즈 제조. 아크릴 콘택트렌즈는 단량체인 HEMA(8.0 g), NVP(1.0 g), MMAc(0.5 g), DMA(0.5 g) 및 TEGDMA(0.05 g)를 상온에서 2시간 교반하여 잘 섞어 준 후, 이들 혼합액에 열개시제인 AIBN(0.1 g)을 추가하고 2시간 교반하여 아크릴 콘택트렌즈 제조용 혼합 반응물을 준비하였다. 최종 혼합 반응물을 폴리프로필렌 몰드에 주입하고 아르곤을 처리하면서 70 ℃에서 12시간 열중합을 진행하였다. 반응 종료 후에 몰드에서 탈착한 아크릴 콘택트렌즈를 24시간 동안 DPBS에서 세척하여 미반응 단량체 및 개시제를 제거하였다.
포스포릴콜린 고분자와 천연 폴리페놀 코팅. 아크릴 콘택트렌즈에 항산화성, 항균성 및 단백질 침착 억제능을 부여하기 위해서 먼저 표면 처리할 코팅액을 제조하였다. 히아루론산(1.0 g), MPC(2.0 g 또는 4.0 g) 및 EGCG(0.15 g)를 증류수 100 mL에 녹이고 가교제인 N,N'-methylenebisacrylamide를 히아루론산과 MPC 무게 대비 2 wt% 사용하고, 개시제인 potassium persulfate를 1 wt% 사용하여 코팅액을 제조하였다. 미리 제조된 아크릴 콘택트렌즈의 앞면과 뒷면을 각 10초씩 산소플라즈마 처리한 후 코팅 용액에 침적시켜 아르곤 처리하면서 50 ℃에서 6시간 반응시키고 세척하여 포스포릴콜린 고분자와 천연 폴리페놀이 코팅된 아크릴 콘택트렌즈를 제조하였다. MPC를 2.0 g 사용하여 코팅한 콘택트렌즈를 MPC2라 표기하고, 4.0 g 사용하여 코팅한 콘택트렌즈를 MPC4라고 표기하였다. 계속해서 MPC에 EGCG를 추가하여 코팅한 콘택트렌즈를 MPC2EG 및 MPC4EG라 각각 표기하였다.
콘택트렌즈 특성 분석. 포스포릴콜린 고분자와 천연 폴리페놀인 EGCG가 코팅된 아크릴 콘택트렌즈의 표면 특성은 scanning electron microscope(SEM, Mira III, TESCAN, Czech Republic)를 이용하여 관찰하였다. SEM을 이용하여 표면을 관찰하기 전에 백금(Pt)을 이용하여 콘택트렌즈 표면을 60초 동안 코팅하였고, 관찰 시에 가속전압을 5.0 kV로 고정하여 관찰하였다. 또한 콘택트렌즈의 표면 화학구조는 X-ray photoelectron spectroscopy(XPS, NEXSA, ThermoFisher Scientific, USA)를 이용하여 분석하였다. 콘택트렌즈의 인장강도(tensile strength)는 12시간 동안 수화된 샘플로 10 kN 용량의 load cell이 장착되어 있는 인장시험기(AGS-X, Shimadzu, Japan)를 이용하여 측정하였다. 콘택트렌즈의 산소투과도는 온도 35 ℃ 및 상대습도 95%가 유지되는 상태에서 polarographic 방법으로 O2 permeometer(201T, Createch Rehder, USA)를 이용하여 측정하였고, 콘택트렌즈 표면의 접촉각은 drop shape analyzer(DSA30, KRÜSS GmbH, Germany)를 이용하여 측정하였다. 수화된 렌즈들의 가시광선 투과율은 Thermo Scientific Evolution 201 UV-Visible Spectrophotometer (Thermo Scientific, USA)이용하여 측정하였다. 제조된 콘택트렌즈의 함수율은 렌즈를 과량의 DPBS에 1시간 동안 침지시킨 후 표면의 수분을 제거하고 수화된 렌즈의 질량을 측정하여 아래의 식 (1)을 이용하여 계산하였다. 여기서 Wwet는 수화된 렌즈의 무게, Wdry는 건조된 렌즈의 무게를 말한다.

라디칼 제거능 평가. 콘택트렌즈의 항산화성을 알아보기 위한 방법으로 DPPH 및 ABTS 라디칼 제거능을 조사하였다. DPPH 라디칼 제거능은 에탄올을 용매로 이용하여 제조한 0.2 mM DPPH 2.7 mL가 들어있는 갈색 바이알에 렌즈 샘플(각 2개)을 침지시킨 후 37 ℃에서 30분간 반응 후에 517 nm에서의 용액의 흡광도 변화를 UV-visible spectrometer(U-2900, Hitachi, Japan)를 이용하여 측정하였다. ABTS를 이용한 라디칼 제거능은 증류수에 3.7 mM ABTS와 1.2 mM potassium persulfate를 녹여 24시간 암실에서 반응시킨 후 이들 용액 2.7 mL가 들어있는 갈색 바이알에 렌즈 샘플(각 2개)을 침지시킨 후 37 ℃에서 30분간 반응 후에 734 nm에서의 용액의 흡광도 변화를 UV-visible spectrometer를 이용하여 측정하였다. 라디칼 제거능은 식 (2)를 이용하여 계산하였고 여기서 ODcontrol은 DPPH 또는 ABTS 용액 단독의 흡광도를 말하고, ODsample는 렌즈를 침지시켜 반응이 완료된 DPPH 또는 ABTS 용액의 흡광도를 말한다.

단백질 흡착 정량. 눈물에 함유되어 있는 단백질 성분은 대부분이 알부민, 글로불린, 리소자임으로 구성되어 있으므로 이들 단백질을 이용하여 콘택트렌즈에 흡착되는 단백질의 양을 분석하였다.13 먼저 DPBS를 이용하여 알부민은 5.4 mg/mL 농도로 제조하였고, 글로불린과 리소자임은 1.8 mg/mL의 농도로 제조하여 단백질 용액을 준비하였다. 바이알에 단백질 용액 각 5 mL을 넣고 미리 준비한 콘텍트렌즈를 침적시켜 37 ℃에서 24시간 동안 단백질을 흡착시킨 후 DPBS를 이용하여 렌즈를 2회 세척하였다. 세척 완료 후 2% sodium dodecyl sulfate(SDS) 완충 용액 1 mL에 콘택트렌즈를 넣고 95 ℃에서 1시간 가열한 후 상온에서 30분 동안 냉각시켜 콘택트렌즈 표면에 흡착된 단백질을 추출하였다. 콘택트렌즈 표면에 흡착된 단백질의 양은 형광법을 이용하여 정량하였다. Fluorescamine은 1차 아미노산을 가진 화합물과 반응해서 형광물질을 생성하므로 단백질 정량에 유용하게 이용되는 물질이다.20 30 mg의 fluorescamine을 100 mL의 DMSO에 녹여서 샘플 용액과 9:1로 혼합하여 상온에서 5분간 반응시켜 fluorescamine-단백질 복합체인 형광물질을 형성시켜 Ex/Em = 390/475 nm에서 형광강도를 측정하여 흡착된 단백질을 정량하였다.
항균 특성 평가. 포스포릴콜린 고분자와 천연 폴리페놀이 코팅된 콘택트렌즈의 항균 특성을 평가하기 위해서 그램 음성균인 대장균(E. Coli, ATCC 10536)과 포도상구균(Staphylococcus aureus, ATCC 6548)을 한국미생물보존센터(KCCM)에서 구입하여 사용하였고, Tryptic Soy Broth 배지를 사용하여 배양하였다. Tryptic Soy Broth 배지에서 미리 배양된 대장균 또는 포도상구균을 0.9% NaCl 용액으로 희석하여 접종할 균주의 농도가가 100 CFU 이하가 되도록 만들어 둔다. 렌즈를 샘플별로 3개씩 4.5 mL의 0.9% NaCl 용액에 담구어서 37 ℃에서 6시간 균질배양기에서 처리하고, 이들 콘택트렌즈가 들어 있는 용액에 0.5 mL의 균액을 혼합하여 37 ℃에서 24시간 배양한다. 배양 완료 후 이들 혼합용액을 0.9% NaCl 용액으로 대장균은 1000배 희석하고 포도상구균은 10배 희석하였다. 계속해서 이들 최종 용액 0.1 mL를 Tryptic Soy Agar에 도말하고 48시간 추가 배양하여 형성된 colony 수를 측정하는 것으로 항균 특성을 평가하였다.
천연 폴리페놀 방출. 천연 폴리페놀인 EGCG가 코팅된 아크릴 콘택트렌즈에서의 EGCG 방출 거동을 UV-visible spectrometer를 이용하여 7일동안 정량하였다. 먼저 DPBS 4 mL가 들어있는 바이알에 렌즈 샘플(각 2개)를 침지시킨 후 37 ℃에서 6일간 배양하면서 용액의 270 nm에서의 흡광도 변화를 시간에 따라 측정하여 EGCG의 방출량을 정량하였다.
통계처리. 모든 실험은 최소 5회 이상 독립적으로 측정하여 그 결과를 평균±표준오차로 나타내었고, 서로 다른 샘플의 통계적 비교는 one-way analysis of variance로 분석하고 SigmaPlot 13.0(Systat Software Inc., USA)을 이용하여 Turkey’s test를 진행하였다. 대조군에 대한 샘플의 유의한 차이는 *p<0.05와 **p<0.01의 수준에서 분석하였다.
포스포릴콜린 고분자와 천연 폴리페놀이 코팅된 아크릴 하이드로젤 콘택트렌즈 특성 분석. 포스포릴콜린 고분자는 단백질 흡착이나 세포 점착을 억제시키는 기능이 있고, 천연 폴리페놀인 EGCG는 항산화성이 매우 우수한 것으로 보고되고 있다.15-19 따라서 본 연구에서는 아크릴 콘택트렌즈에 항산화성과 단백질 흡착 억제능을 부여하기 위해서 미리 제조된 아크릴 콘택트렌즈의 표면을 산소플라즈마 처리한 후 MPC, EGCG, 히아루론산 및 가교제를 이용하여 포스포릴콜린 고분자와 천연 폴리페놀이 코팅된 아크릴 하이드로젤 콘택트렌즈를 제조하였다. 제조된 콘택트렌즈 샘플은 코팅에 사용된 MPC의 함량 및 EGCG의 첨가 여부에 따라서 MPC2, MPC4, MPC2EG 및 MPC4EG로 표기하였고 코팅을 하지 않은 아크릴 콘택트렌즈는 PHEMA로 표기하였다. 이들 콘택트렌즈는 Figure 1(a)에서 볼 수 있는 것처럼 모든 콘택트렌즈 샘플이 육안으로 관찰하였을 때 투명한 형상을 보였으며 높은 광학 투명도를 보이고 있는 것으로 판단되었다. 또한 SEM을 이용한 단면 관찰에서 포스포릴콜린 고분자와 EGCG가 단일 층을 이루고 있음이 관찰되었고, 코팅층의 두께는 MPC2는 2.3 μm, MPC4는 2.5 μm, MPC2EG는 5.7 μm 및 MPC4EG는 5.9 μm로 EGCG가 추가됨에 따라서 코팅층의 두께가 증가하는 것이 확인되었다. 이는 EGCG를 추가함에 의해서 히아루론산과 MPC가 EGCG와 수소결합을 형성하여 코팅액의 점도가 상승한 것에 기인하는 것으로 판단된다. 실제 코팅액의 점도를 측정한 결과 MPC2와 MPC4의 코팅액은 점도가 162 cP 및 167 cP였으나 EGCG를 추가함에 따라서 코팅액의 농도가 179 cP 및 186 cP로 증가하였다.
포스포릴콜린 고분자와 천연 폴리페놀이 코팅된 아크릴 하이드로젤 콘택트렌즈의 MPC 및 EGCG의 사용에 따른 코팅층의 화학적 조성 변화는 XPS를 이용하여 확인하였다. 코팅을 하지 않은 PHEMA 렌즈에서는 아크릴 고분자와 NVP에 기인하는 3개의 피크가 534 eV(O 1s), 401 eV(N 1s) 및 287 eV(C 1s)에서 관찰되었고, 포스포릴콜린 고분자와 천연 폴리페놀인 EGCG가 코팅된 렌즈에서는 포스포릴콜린 고분자에 기인하는 2개의 피크가 196 eV(P 2s) 및 134 eV(P 2p)에서 새로이 관찰되었다(Figure 2).
포스포릴콜린 고분자와 EGCG의 도입이 렌즈 표면의 친수화에 미치는 영향을 알아보기 위해서 코팅에 따른 접촉각 변화를 측정하였다. Figure 3에서 볼 수 있는 것처럼 접촉각은 52°-64°의 값을 나타내었다. 코팅 처리를 하지 않은 아크릴 콘택트렌즈의 경우 64°의 접촉각을 보였으나 포스포릴콜린 고분자 및 EGCG의 도입에 따라 접촉각은 52°까지 낮아졌으며 코팅층에 포스포릴콜린 고분자의 도입량이 많아질수록 친수화에 의해 접촉각이 낮아짐을 확인하였다. 이는 포스포릴콜린 고분자에 존재하는 쯔비터이온을 중심으로 물분자에 의해 쉽게 수화되기 때문인 것으로 판단된다.18,19 또한 친수성인 EGCG의 사용도 렌즈 표면의 친수화에 영향을 주었다.
포스포릴콜린 고분자와 EGCG의 도입이 렌즈의 친수화에 주는 영향을 다시 확인하기 위해서 제조된 렌즈 샘플을 이용하여 함수율을 측정하였다. 그 결과 PHEMA 렌즈의 경우 40.3%의 함수율을 보였으나 MPC4EG의 경우 45.8%의 향상된 함수율을 보임을 확인하였다(Figure 4(a)). 이 결과는 접촉각 측정 결과와 잘 일치하는 것으로 포스포릴콜린 고분자 및 EGCG의 도입에 의해서 콘택트렌즈의 친수화도가 개선되었음을 확인하였다.
각막의 경우 혈관이 존재하지 않기 때문에 콘택즈렌즈를 착용하게 되면 콘택트렌즈를 통해서 각막에 산소가 전달된다. 만약 각막에 산소가 충분히 전달되지 않는다면 각막 저산소증, 각막 신생혈관 생성, 각막부종 등과 같은 부작용이 발생하게 된다.21 이러한 이유로 콘택트렌즈를 통해서 전달되는 산소의 양을 뜻하는 산소투과율은 Dk/t((cm·mLO2)/(sec·mL·mmHg)·10-9)로 나타내며 각막 대사에 매우 중요한 변수로 작용할 수 있다. Figure 4(b)에서 볼 수 있는 것처럼 코팅 처리하지 않는 PHEMA 렌즈의 경우 8.8의 낮은 산소투과율을 보였으나 포스포릴콜린 고분자와 EGCG의 코팅으로 산소투과율이 50% 이상 개선되어 MPC4EG 렌즈의 경우 13.4의 높은 산소투과율을 보였다. 하이드로젤 콘택트렌즈의 경우 렌즈에 함침된 물분자에 의해서도 산소가 전달되기 때문에 함수율에 비례하여 산소투과율이 높아지는 것으로 보고되고 있다.22 따라서 함수율이 개선된 포스포릴콜린 고분자와 EGCG가 코팅된 하이드로젤 콘택트렌즈의 경우 PHEMA 렌즈에 비해서 높은 산소투과율을 보이는 것으로 판단되어진다.
하이드로젤 콘택트렌즈의 중요한 특성 중의 하나가 광학 투명도이다. 그러나 콘택트렌즈의 항산화성을 극대화하기 위해서는 청색광에 의한 ROS의 생성을 억제하여야 하며, 이를 위해서는 콘택트렌즈에 청색광 차단 효과가 있어야 한다. 이들 특성을 평가하기 위해서 제조된 하이드로젤 콘택트렌즈의 자외선 및 가시광선 투과율을 자외선-가시광선 흡수 분광법을 이용하여 분석하였다. PHEMA, MPC2 및 MPC4 렌즈의 경우 가시광선을 산란시키는 물질이 없기 때문에 300 nm 이상 파장대의 모든 빛을 95% 이상 통과시키는 것으로 확인되었다(Figure 5(a)).
그러나 EGCG가 도입된 MPC2EG 및 MPC4EG의 경우 안구에 유해한 청색광 영역으로 알려진 380-450 nm 파장영역의 빛을 최대 약 25% 정도 차단하는 효과를 보였다. 또한 자외선(UV-B)의 경우 대부분을 차단하는 효과도 보였다. 이는 MPC와 EGCG를 이용하여 콘택트렌즈를 코팅하는 반응 과정과 제조된 콘택트렌즈를 DPBS에 보관하는 동안 EGCG의 자동산화반응(autoxidation)에 의해서 생성되는 EGCG quinone에 청색광의 일부가 흡수되기 때문이다.21 그러나 500 nm 이상의 파장영역에서는 EGCG가 도입되지 않는 렌즈와 동일하게 높은 가시광선 투과율을 보였다. 제조된 하이드로젤 콘택트렌즈의 기계적 특성 변화를 알아보기 위해서 응력-변형 측정을 기초로 하여 인장강도(tensile strength)를 측정하였다(Figure 5(b)). 그 결과 포스포릴콜린 고분자와 EGCG의 코팅으로 콘택트렌즈의 기계적 특성이 약간 개선되기는 하였지만 급격한 인장강도의 증가는 관찰되지 않았다.
항산화성 평가. 포스포릴콜린 고분자와 EGCG가 코팅된 하이드로젤 콘택트렌즈의 항산화성은 DPPH 및 ABTS 라디칼 제거능 분석을 통해서 평가하였다. DPPH 라디칼의 경우 517 nm에서 강한 흡광도를 보이지만 항산화제와의 반응에 의해서 안정한
hydrazine으로 환원될 경우 517 nm에서의 흡광도가 감소하므로 이를 이용하여 콘택트렌즈의 DPPH 라디칼 제거능을 평가한 결과 EGCG가 도입되지 않는 콘택트렌즈의 라디칼 제거능이 전혀 관찰되지 않았으나 EGCG의 도입에 의해서 약 85%의 DPPH 라디칼이 제거되었다(Figure 6).
포스포릴콜린 고분자와 EGCG가 코팅된 하이드로젤 콘택트렌즈의 항산화성을 확인하기 위해서 DPPH와는 다른 형태인 라디칼 양이온을 형성하고 있는 ABTS를 이용하여 734 nm에서의 흡광도 세기의 감소에 따라 라디칼 제거능을 평가하였다. 그 결과 EGCG가 도입되지 않는 콘택트렌즈의 라디칼 제거능이 매우 낮은 값을 보였으나 EGCG의 도입에 의해서 약 99%의 ABTS 라디칼이 제거되었다(Figure 7). 제조된 콘택트렌즈는 DPPH 및 ABTS 라디칼에 대한 유사한 양상의 라디칼 제거능을 보였고, 그 결과로부터 포스포릴콜린 고분자와 EGCG가 코팅된 하이드로젤 콘택트렌즈는 매우 우수한 항산화성을 보인다는 것을 알 수 있었다. 이는 천연 폴리페놀이 라디칼 제거를 위한 연쇄반응 중에서 알킬 라디칼을 환원시켜 라디칼을 제거함과 동시에 그 자신이 비교적 안정적인 폴리페놀 라디칼을 형성하는 반응에 기인한다.15,23
단백질 흡착 거동. 콘택트렌즈 표면에의 단백질 흡착은 장시간 렌즈를 착용하였을 때의 착용감 저하와 같은 문제뿐만 아니라 다양한 안질환을 유발하는 문제점을 가지고 있다.14 또한 단백질의 흡착은 세균에 의한 감염이나 면역반응을 유발하기도 한다. 따라서 제조된 콘택트렌즈를 이용하여 단백질 흡착 거동을 형광분석법을 이용하여 정량하였다. Figure 8에서 볼 수 있는 것처럼 코팅 처리하지 않은 PHEMA 렌즈에서는 측정된 모든 단백질에서 높은 흡착 거동을 보였으나 포스포릴콜린 고분자가 코팅된 콘택트렌즈의 경우 단백질 흡착이 많이 억제되는 것을 관찰할 수 있었다. 특히 포스포릴콜린 고분자의 도입량이 많아 질수록 콘택트렌즈 표면에서의 단백질 흡착은 더 효과적으로 억제됨을 알 수 있었다. 포스포릴콜린 고분자의 도입이 단백질 흡착 억제에 직접적인 영향을 미친다는 것을 증명하기 위해서 포스포릴콜린 고분자가 없이 히아루론산과 가교제 성분만을 이용하여 코팅한 HA 렌즈의 경우 콘택트렌즈의 표면 친수화에 따른 단백질 흡착 억제 효과는 있으나 포스포릴콜린 고분자가 코팅된 콘택트렌즈에 비해서는 낮은 단백질 흡착 억제능을 보였다.24 본 실험에서 사용된 3가지의 단백질 중에서 리소자임이 대부분의 콘택트렌즈에서의 흡착량이 가장 많은 것으로 평가되었다. 이는 리소자임의 분자량이 상대적으로 작기 때문에 콘택트렌즈의 표면에서 확산되고 흡착되는 거동을 보이기 때문이다.14 계속해서 EGCG의 도입이 단백질 흡착 거동에 미치는 영향을 평가한 결과 EGCG의 사용은 콘택트렌즈 표면의 물리화학적 특성 변화에 많은 영향을 미치지 않았고, 그 결과 단백질 흡착에도 거의 영향을 미치지 않는 것으로 판단되었다.
항균 특성 평가. 콘택트렌즈의 경우 안구에 직접 접촉하여 착용되기 때문에 세균에 의한 렌즈 표면의 오염은 세균성 안질환을 유발할 뿐만 아니라 바이오 필름의 형성을 촉진한다.22 형성된 바이오 필름은 단백질 흡착을 촉진하여 산소투과도를 떨어뜨리는 것과 같이 콘택트렌즈의 특성 저하도 유발하기 때문에 장시간 렌즈 착용을 가능하게 하기 위해서는 항산화성과 더불어 콘택트렌즈에 항균 특성의 부여가 필요하다. 따라서 본 연구에서는 포스포릴콜린 고분자와 EGCG가 코팅된 하이드로젤 콘택트렌즈의 항균 특성을 평가하기 위해서 감염성 안질환을 가장 많이 유발하는 원인균인 포도상구균(Staphylococcus aureus)과 대표적인 그램 음성균인 대장균(E. Coli)을 이용하였다.
코팅 처리를 하지 않은 PHEMA 렌즈를 대조군으로 하고 포스포릴콜린 고분자와 EGCG가 코팅된 콘택트렌즈의 항균 특성을 시험한 결과 포스포릴콜린 고분자가 렌즈의 표면에 도입됨에 의해서 포도상구균과 대장균 모두에 대해서 약 40% 정도의 항균 특성이 개선됨을 알 수 있었다(Figures 9 and 10). 이는 포스포릴콜린 고분자가 렌즈표면에 코팅됨에 따라서 포도상구균 및 대장균이 렌즈 표면에 부착되는 것이 억제되어 나타나는 현상으로 판단된다.14 또한 포스포릴콜린 고분자의 측쇄에 존재하는 4차 암모늄염에 의해 포도상구균과 대장균의 세포막이 파괴되어 항균 특성이 나타나는 것으로 판단되어 진다.24 특히 포스포릴콜린 고분자와 더불어 EGCG가 도입된 콘택트렌즈에서는 모든 샘플에서 99.9% 이상의 포도상구균 및 대장균 감소율을 보였다. 이 결과는 EGCG에 존재하는 많은 hydroxyl group(-OH)과 세균의 단백질에 존재하는 sulfhydryl group(-SH)과의 반응 또는 펩티도글리칸(peptidoglycan)과의 결합성 상호작용에 의해서 발현된다.17,25 특히 C6-C3 구조를 가진 플라보노이드류(flavonoids)는 세균의 세포막과 복합체를 형성하여 세포막을 파괴시키거나, 지방산 합성 및 세균 내에 존재하는 효소의 활성을 저해함에 의해서 항균 특성을 보이는 것으로 알려져 있다.
Figures 9와 10은 포도상구균과 대장균에 대한 포스포릴콜린 고분자 및 EGCG가 코팅된 콘택트렌즈의 항균 특성 실험 후 37 ℃에서 24시간 동안 배양한 후 Tryptic Soy Agar plate에 형성된 포도상구균과 대장균의 콜로니 사진이다. 대조군으로 사용된 PHEMA 렌즈에는 많은 수의 콜로니가 형성되어 있음이 관찰되었지만 포스포릴콜린 고분자와 EGCG의 도입에 의해서 콘택트렌즈가 포도상구균 및 대장균 모두에 대해서 우수한 항균 특성을 보임을 확인할 수 있었다.
천연 폴리페놀 방출. 포스포릴콜린 고분자와 천연 폴리페놀인 EGCG가 코팅된 하이드로젤 콘택트렌즈의 우수한 항산화성과 항균성은 콘택트렌즈로부터 방출된 EGCG의 영향으로 판단되어 시간의 경과에 따른 EGCG의 방출 거동을 조사하였다. 그 결과 Figure 11에서 볼 수 있는 것처럼 MPC2EG와 MPC4EG에서의 EGCG 방출 거동의 거의 유사한 경향성을 보였고, 친수성이 좀 더 개선된 MPC4EG에서 EGCG의 방출량이 매우 조금 증가한 것을 알 수 있었다. 또한 초기에는 표면에 흡착된 EGCG가 빠른 속도로 방출되지만 내부에 함유된 EGCG는 시간의 경과에 따라 서서히 방출되었고, 장시간에 걸쳐서 서서히 방출되는 것을 확인할 수 있었다. 이들 결과로부터 포스포릴콜린 고분자와 EGCG가 코팅된 콘택트렌즈의 경우 장시간 착용이 가능할 것으로 판단된다.

|
Figure 1 (a) Digital images; (b) cross-sectional SEM micrographs of acryl hydrogel contact lenses coated with phosphorylcholine polymer and natural polyphenol. |

|
Figure 2 (a) XPS survey scan spectra of acryl hydrogel contact lenses; high-resolution XPS (b) P 2s; (c) P 2p spectra for acryl hydrogel contact lenses. |

|
Figure 3 Photographs of water droplets on the external surface of (a) PHEMA; (b) MPC2; (c) MPC4; (d) MPC2EG; (e) MPC4EG hydrogel contact lenses; (f) Average water contact angles of acryl hydrogel contact lenses determined by analyzing the photographs (n=5). |

|
Figure 4 (a) Water content; (b) oxygen transmissibility of acryl hydrogel contact lenses (n=5). |

|
Figure 5 (a) Transmittance spectra; (b) tensile strength of acryl hydrogel contact lenses (n=5). |

|
Figure 6 (a) Absorption spectra of DPPH radical solutions after scavenging reaction with hydrogel contact lenses; (b) DPPH radical scavenging activities of hydrogel contact lenses (n=5). |

|
Figure 7 (a) Absorption spectra of ABTS radical solutions after scavenging reaction with hydrogel contact lenses; (b) ABTS radical scavenging activities of hydrogel contact lenses (n=5). |

|
Figure 8 Amount of various proteins adsorbed on the surface of acryl hydrogel contact lenses (n=5). |
|
Figure 9 Antibacterial activities of acryl hydrogel contact lenses: (a) PHEMA; (b) MPC2; (c) MPC4; (d) MPG2EG; (e) MPC4EG. (f) average colonies count of Staphylococcus aureus after incubation with extraction solutions from acryl hydrogel contact lenses (n=5) |

|
Figure 10 Antibacterial activities of acryl hydrogel contact lenses: (a) PHEMA; (b) MPC2; (c) MPC4; (d) MPG2EG; (e) MPC4EG. (f) average colonies count of E. Coli after incubation with extraction solutions from acryl hydrogel contact lenses (n=5). |

|
Figure 11 Cumulative release profile of EGCG from MPC2EG and MPC4EG in DPBS at 37 ℃ (n=3). |
최근 항산화성 부여, 청색광 차단, 단백질 비흡착 등과 같은 유용한 기능성을 구현할 수 있는 하이드로젤 콘택트렌즈의 개발이 야외 활동의 증가 및 전자 기기의 장시간 사용에 따른 ROS의 발생에 기인하는 안질환을 방지하고, 또한 콘택트렌즈의 장시간 착용에 따른 부작용을 줄이기 위해서 많이 연구되고 있다. 본 연구에서는 자외선 및 청색광에 의한 ROS의 생성을 억제시킬 뿐만 아니라 제거 효율도 극대화시키고, 또한 콘택트렌즈 표면에 단백질 흡착을 억제시켜 콘택트렌즈의 장시간 착용이 가능하고 항균성도 부여함에 의해서 항산화성과 단백질 흡착 억제능을 극대화할 수 있는 아크릴 하이드로젤 콘택트렌즈를 포스포릴콜린 고분자와 천연 폴리페놀인 EGCG를 렌즈의 표면에 코팅하는 방법을 통해서 제조하였다. 제조된 하이드로젤 콘택트렌즈는 코팅 처리하지 않은 PHEMA 렌즈 보다 많이 개선된 산소투과율을 보였고, 청색광 영역에서는 차단효과가 있었지만 500 nm 이상의 가시광선 영역에서는 높은 광투과율을 보였다. 특히 DPPH 및 ABTS 라디칼에 대해서 매우 우수한 항산화성을 보였고, 눈물에 포함되어 있는 단백질에 대해서는 효과적인 단백질 흡착 억제능을 보였다. 또한 감염성 안질환을 가장 많이 유발하는 원인균인 포도상구균과 대표적인 그램 음성균인 대장균에 대해서 매우 우수한 항균성을 보였다. 이들 결과로부터 포스포릴콜린 고분자와 EGCG가 코팅된 아크릴 하이드로젤 콘택트렌즈의 제조는 새로운 기능성이 부여된 콘택트렌즈의 개발에 많은 도움이 될 것으로 기대되어 진다.
- 1. Choi, S. J.; Jung, J.; Lee, K.-H.; Park, J. Y. Biofilm Formation and Its Related Gene Expression in Staphylococcus Aureus on Different Materials of Soft Contact Lenses. J. Korean Ophthalmic Opt. Soc. 2017, 22, 205-212.
-

- 2. Yang, J.-M.; Kim, H.-J.; Cho, B.-K. Preparation of Antioxidant Hydrogel Contact Lenses via Copolymerization of Dopamine Monomer. Polym.Korea 2019, 43, 787-792.
-

- 3. Sahabudeen, H.; Machatschek, R.; Lendlein, A. Multifunctionality as Design Principle for Contact Lens Materials. Multifunct. Mater. 2021, 4, 042001.
-

- 4. Kang, D.-Y.; Kwon, G.-W.; Jung, K.-H.; An, S.-H.; Kang, I.-K. Drug-release Performance of Acrylic Hydrogel Membranes Synthesized Using a Novel Cross-linker. Polym. Korea 2016, 40, 628-634.
-

- 5. Lee, J. O.; Narashimhan, V.; Du, J.; Ndjamen, B.; Sretavan, D.; Choo, H. Biocompatible Multifunctional Black-silicon for Implantable Intraocular Sensor. Adv. Healthcare Mater. 2017, 6, 1601356.
-

- 6. Jeon, H.-J.; Kim, S.; Park, S.; Jeong, I.-K.; Kang, J.; Kim Y. R.; Lee, D. Y. Optical Assessment of Tear Glucose by Smart Biosensor Based on Nanoparticle Embedded Contact Lens. Nano Lett. 2021, 21, 8933-8940.
-

- 7. Zhao, L.; Wang, H.; Feng, C.; Song, F.; Du, X. Preparation and Evaluation of Starch Hydrogel/contact Lens Composites as Epigallocatechin Gallate Delivery Systems for Inhibition of Bacterial Adhesion. Front. Bioeng. Biotechnol. 2021, 9, 759303.
-

- 8. Nakanishi-Ueda, T.; Majima, H.J.; Watanabe, K.; Ueda, T.; Indo, H.P.; Suenaga, S.; Hisamitsu, T.; Ozawa, T.; Yasuhara, H.; Koide, R. Blue LED Light Exposure Develops Intracellular Reactive Oxygen Species, Lipid Peroxidation, and Subsequent Cellular Injuries in Cultured Bovine Retinal Pigment Epithelial Cells. Free Radic. Res. 2013, 47, 774-780.
-

- 9. Nita, M.; Grzybowski, A. The Role of the Reactive Oxygen Species and Oxidative Stress in the Pathomechanism of the Age-related Ocular Diseases and Other Pathologies of the Anterior and Posterior Eye Segments in Adults. Oxidative Med. Cell Longev. 2016, 2016, 3164734.
-

- 10. Yang, J.-M.; Kim, H.-J.; Cho, B.-K. Preparation of Antioxidant Hydrogel Contact Lenses Based on Interpenetrating Hyaluronic Acid Network. Polym. Korea 2020, 44, 21-29.
-

- 11. Kang, S.; Hong, J. E.; Choi, E. J.; Lyu, J. Blue-light Induces the Selective Cell Death of Photoreceptors in Mouse Retina, J. Korean Ophthalmic Opt. Soc. 2016, 21, 69-71.
-

- 12. Park, M. Design of a Coated Blue-light Blocking Lens and Study of Its Optical Characteristics According to the Blue-light Blocking Rate. J. Korean Ophthalmic Opt. Soc. 2019, 24, 301-307.
-

- 13. Lee, J.-Y.; Lee, J.-I.; Kim, S. R.; Park, M. Correlation Between Tear Proteins Deposition and Oxygen Transmissibility of Soft Contact Lenses. J. Korean Ophthalmic Opt. Soc. 2017, 22, 97-103.
-

- 14. Ishihara, K.; Fukazawa, K.; Sharma, V.; Liang, S.; Shows, A.; Dunbar, D. C.; Zheng, Y.; Ge, J.; Zhang, S.; Hong, Y.; Shi, X.; Wu, J. Y. Antifouling Silicon Hydrogel Contact Lenses With a Bioinspired 2-methacryloyloxyethyl Phophorylcholine Polymer Surface. ACS Omega 2021, 6, 7058-7067.
-

- 15. Singh, B. N.; Shankar, S.; Srivastava, R. K. Green Tea Catechin, Epigallocatechin-3-gallate (EGCG): Mechanism, Persfectives and Clinical Applications. Biochem. Pharmacol. 2011, 82, 1807-1821.
-

- 16. Ferrari, E.; Bettuzzi, S.; Naponelli, V. The Potential of Epigallocatechin Gallate (EGCG) in Targeting Autophagy for Cancer Treatment: A Narrative Review. Inter. J. Mol. Sci. 2022, 23, 6075.
-

- 17. Osterburg, A.; Gardner, J.; Hyon, S. H.; Neely, A.; Babcock, G. Highly Antibiotic-resistant Acinetobacter Baumannil Clinical Isolates are Killed by the Green Tea Polyphenol (-)-epigallocatechin-3-gallate (EGCG). Clin. Microbiol. Infect. 2009, 15, 341-346.
-

- 18. Kojima, C.; Katayama, R.; Nguyen, T. L.; Oki, Y.; Tsujimoto, A.; Yusa, S.-I.; Shiraishi, K.; Matsumoto, A. Different Antifouling Effects of Random and Block Copolymers 2-methacryloyloxyethyl Phosphorylcholine and Dodecyl Methacrylate. Eur. Polym. J. 2020, 136, 109932.
-

- 19. Seetasang, S.; Xu, Y. Recent Progress and Perspectives in Applications of 2-methacryloyloxyethyl Phosphorylcholine Polymers in Bioactives at Small Scales. J. Mater. Chem. B 2022, 10, 2323-2337.
-

- 20. Deryea, S. M.; Samir, E. A Review on the Use of Fluorescamine as Versatile and Convenient Analytical Probe. Microchem. J. 2020, 156, 104835.
-

- 21. Nichols, J. J.; Ziegler, C.; Mitchell, G. L.; Nichols, K. K. Self-reported Dry Eye Disease Across Refractive Modalities. Investig. Ophthalmol. Vis. Sci. 2005, 46, 1911-1914.
-

- 22. Ko, N.-Y.; Lee, H. M. Effect of Ionic Natural Polysaccharides on the Functional Enhancement of Porous Hydrogel Contact Lenses. Polym. Korea 2020, 44, 625-632.
-

- 23. Ouyang, J.; Zhu, K.; Liu, Z.; Huang J. Prooxidant Effects of Epigallocatechin-3-gallate in Health Benefits and Potential Adverse Effect. Oxid. Med. Cell. Longev. 2020, 9723686.
-

- 24. Kim, H. J.; Kim, K. H.; Han, Y. S.; Kim, Y.-J.; Lee, H. M. Antioxidant and Physical Properties of Dual-networked Contact Lenses Containing Quercetin Using Chitosan and Alginate. Macromol. Res. 2022, 30, 737-744.
-

- 25. Reygaert, W. C. The Antimicrobial Possibilities of Green Tea. Front. Microbiol. 2014, 5, 434.
-

- Polymer(Korea) 폴리머
- Frequency : Bimonthly(odd)
ISSN 0379-153X(Print)
ISSN 2234-8077(Online)
Abbr. Polym. Korea - 2025 Impact Factor : 1.0
- Indexed in SCIE
 This Article
This Article
-
2024; 48(2): 148-157
Published online Mar 25, 2024
- 10.7317/pk.2024.48.2.148
- Received on Sep 13, 2023
- Revised on Nov 17, 2023
- Accepted on Dec 29, 2023
 Services
Services
Shared
 Correspondence to
Correspondence to
- Young-Jin Kim
-
Department of Advanced Materials and Chemical Engineering, Daegu Catholic University, Gyeongsan 38430, Korea
- E-mail: yjkim@cu.ac.kr
- ORCID:
0000-0002-1153-1304








 Copyright(c) The Polymer Society of Korea. All right reserved.
Copyright(c) The Polymer Society of Korea. All right reserved.